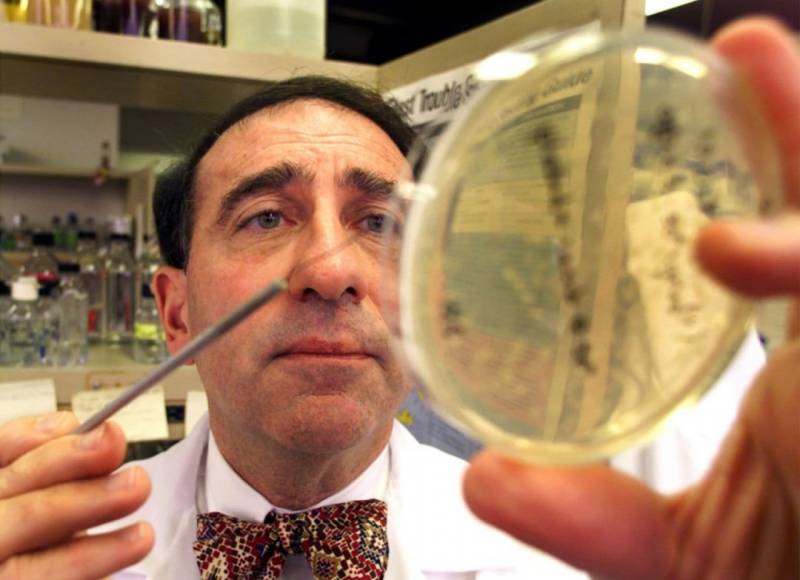

意外!新加坡人十大毙 命原因出炉,这些华人的吃药和生活习惯要改了
如果说起“致命疾病”
你会想到什么?
癌症?心脑血管疾病?白血病...
新加坡公布十大死因
其中,竟然有 尿路感染?!

图源:亚洲新闻台
这简直出乎一般人的意料
更加意外的是这一切
竟然和“抗生素有关”
报告信息量超级大
和每个生活在新加坡的华人息息相关
也和大家生活习惯
用药习惯,有着强烈的联系

*示意图
这些,你应该要了解!
新加坡10大死亡原因
中风,心脑血管疾病,癌症等
是致命疾病,并不令人意外
也比较符合我们的认知

*中风,癌症等符合想像,《柳叶刀》数据。
但是,新加坡十大死因里面
竟出现了尿路感染
真的,显得有那么点突兀

*来源:新加坡卫生部官网
这些新加坡相关病例
看得大家沉默了!
“小炎症,怎么就治不好了?”
A小姐尿路感染严重,苦不堪言
但是,抗生素吃了一个疗程也没好
去检查才发现感染了“大肠杆菌”
这个细菌其实没什么攻击性
怎么就把她折磨成这样?
她体内大肠杆菌
对治疗药物产生耐药性了
抗生素变得无效

“小炎症,怎么就得住院了?”
S小姐的情况更悲催
一次手术过后她患上了尿路感染
吃了两个疗程抗生素也没好
当她再接受检查时
感染已经扩散到肾脏了!
如果不赶快治疗
甚至会永久性肾脏损伤
她立即接受了治疗
并静脉注射了抗生素
S小姐这次“脱险了”

示意图
但是医生警告她
如果她再次感染细菌
就需要住院治疗
新加坡治疗尿路感染
病人都会要求想吃抗生素
然而在不必要时服用
可能会产生一种被称为“超级病菌”
的多重耐药性细菌
这个东西,会非常棘手

*示意图
要避免这情况发生
就应该在有需要时
才服用抗生素
显然,很多在新加坡的小伙伴并不买账
执意在“吃错了药”
这条路上越走越远...
你的吃药习惯,可能摧毁你健康
“不吃抗生素?”一般人做不到
不光是尿路感染
发烧感冒都是一一样的...
“我儿子都烧到39了
快给他吃抗生素!”
初为人父母看到孩子生病
真的会非常的焦急
恨不得马上就让烧退下去
但是,大家都知道新加坡医生治疗感冒
都非常的佛,先回去吃退烧药一周
烧不退再来开抗生素
静脉注射几乎没看见过
退烧药就那么几种
paracetamol(扑热息痛成分)
ibuprofen(布洛芬成分)


*新移民家长都眼熟了吧
孩子发烧难受
医生就给点退烧药???
着急的父母会吐槽本地医生
甚至要求医生给抗生素
“孩子都好了,还吃什么药?”
还有,新加坡医生开抗生素
总会千叮咛万嘱咐
一定要吃完7天的量(一般是7天)
但是,按照咱以往经验和认知
就是有炎症就吃消炎药
病好了就停止了
孩子外婆常常就说
“不用吃完,病都好了吃什么药”

“新加坡医生太佛系?”
“发烧了,咳嗽了就要点滴、
抗生素一起来?”
“症状消失了就不用吃抗生素了?”
事实真的如我们所想吗?
美国纽约市卫生局(New York City Department of Health)的研究显示,三分之一不复杂的UTI病例对使用最广泛的药物之一,巴克特里姆(Bactrim)产生了耐药性,其中至少五分之一的病例对其他五种常见治疗方法产生了耐药性。
医学杂志《柳叶刀》也提供了类似的惨淡数据。去年发表的一项研究表明,英国超过三分之一的大肠杆菌引起的UTIs对“关键抗生素”有抗药性。
“小炎症,大毛病”
已经在各个国家日益严重了
“ 吃药误区”
昨天,美国微生物学家
Stuart B. Levy去世了
他被称为“抗生素管理之父”
他,在美国率先发现:
用抗生素喂养禽畜
人和禽畜都会耐药
他,终其一生都在研究抗生素滥用
对人、动物和环境的影响
他昨天已经逝去了
但滥用问题仍然严峻
“细菌活过了恐龙时代
我们无法消灭细菌
我们要学习活在细菌时代”
抗生素本身没有任何问题
小孩也可以使用
最重要的是正确的使用
抗生素误区
√ 抗生素对病毒无效
√ 不会加速普通感冒的康复
√ 一定要吃完一个疗程
√ 滥用会产生抗药性
记住!新加坡医生的ABCD口诀:
A=Ask:问自己是否有须要服用抗生素。若是病毒感染,服用抗生素也无济于事,还可能会助长超级病菌的产生。
B=Bacteria:细菌可以被抗生素杀死,但抗生素不会杀死病毒。
C=Complete:完成整个抗生素疗程,按照医生处方。
D= Don't:不要对医生施加压力要求服用抗生素。一般的伤风、感冒,以及多数的咳嗽、支气管炎、由病毒感染引起的喉痛,皆不需要服用抗生素。
以后,当我们看到有人吐槽
新加坡医生不开抗生素
是医术不行的时候
也要想想自己是否走进了
用药习惯误区?
你的生活习惯,可能摧毁你健康
我们再来看看新加坡
十大死亡原因
确实,在这个“闻癌色变”的时代
新加坡也未能幸免
癌症,也是新加坡人的
健康“第一杀手”

再看看这些“健康杀手”
心脑血管疾病,癌症,糖尿病等
跟很多因素有关系
但是,不得不说
不良生活/饮食习惯
要背一锅!

图源:柳叶刀,死亡人数风险归因
1
重口味
膳食风险因素排名第一
那么,我们到底哪里吃错了呢?
全球近20%的死亡与饮食有关
而在饮食导致死亡的统计表中
位列第一名的,竟是高盐
麻小,撸串,火锅
豆豉辣酱,辣条等
这些我们超爱重口味食物
简直就是咸盐本盐

2
吸烟,喝酒等不良嗜好
根据世界卫生组织的数据
一年800万人失去生命就是烟草的锅
二手烟的危害更不用说了吧
说多了也都是眼泪
“饮酒”是国际公认的致癌因素
世界卫生组织早就把
乙醇列为证据确凿的 1类致癌物

3
高糖饮食
小岛天气真是太热
大家都习惯喝冰饮和果汁
糖分特别足
间接的结果就是
糖尿病成了新加坡健康杀手
而且过了60岁之后......

10个华人1个糖尿病
10个马来族有5个糖尿病
10个印度族有6个糖尿病
为了健康
新加坡操碎了心
大根据世界卫生组织的一项调查
新加坡人健康寿命全球最长
新加坡寿命
平均寿命:
新加坡女性平均寿命85.2岁
男性平均寿命82.6岁
健康寿命:
新加坡女性新生儿
健康平均寿命77.6岁
男性是74.7岁

为了国民健康长寿
新加坡可谓操碎了心!
除此之外,你也会发现新加坡
在国民健康问题上
可谓是 “铁腕规则”
1
全岛抗糖
大家最近觉不觉得
新加坡的饮料都不那么甜了?
这就是政府抗糖举措之一
给饮料减糖
最近就连点麦当当
也只有少糖和无糖的选择
并没有原味可乐了

2
全民健康
大家可能也留意到了
这些饮品上有一个标志
这是新加坡健康促进局推出的
较健康选择标志
Healthier Choice

新加坡,已有超过3500种商品
获得这个标志了
而且,超市和政府会用各种手段促销
让大家选择这个标志的食品
3
全面禁止反式脂肪
2021年,新加坡即将
全面禁止反式脂肪
反式脂肪普遍
存在于一些加工食品之中
可能导致肥胖
甚至是心脑血管疾病

4
禁烟禁酒令
大家知道新加坡禁烟酒
手段相当“简单粗暴”
最高烟酒税之一
最严格的禁酒令之一
让烟酒在新加坡可谓
又贵又难买到

*新加坡卖烟不得公开展示
5
抗生素严格使用
新加坡对于抗生素一直严格控制
含有抗生素的药物
严格属于处方药
在外面不能随意买到
控制,督导,教育都跟上
卫生部说这些活动是政府
对抗抗生素耐药性
全国战略计划的重要部分

虽然新加坡看病很贵
一直是超级大槽点
《World Health Report》
对全球各国的医疗体系进行了比较
最后按照预期寿命进行了排名
新加坡医疗全球第三

人身安全也比较有保障
减少外部因素风险

印尼邻居不烧芭
新加坡的空气还是清新甜美的~

食品安全,而且还有更多
健康选择

加上一系列的“铁腕规则”
新加坡国民健康不愁了~

最近,大家是不是越来越
关心自己的健康了?
比如,看到这样的内容
心里也会发怵?

图源:新闻晨报
其实,几乎每个人都是如此
像我们在海外这群人
没有根基,大家都会格外努力
没日没夜的工作学习
为了站稳脚跟,为了身份
为了不辜负爸妈一片心
我们,做的一切都是拼尽了全力

殊不知,可能过度透支自己的身体
当时间不可逆转
当身体不再健康时
再追悔莫及已经无济于事了
健康生活,从今天开始~






















评论